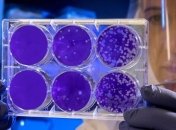
"Біофарма" починає проводити ІФА-тести донорів плазми, які перенесли COVID-19

COVID-19
-
![Гончаренко: Коронавірус виявили у нардепа від Батьківщини]()
Коронавірус виявили у ще одного народного депутата
-
![Коронавірус: Канада й США залишають спільний кордон закритим]()
Канада і США залишать спільний кордон закритим ще на місяць
-
![Разумков: Наші лікарі працюють на 110 %, у чиновників показник буде все ж таки менше]()
Разумков говорить, що оцінку керівництву МОЗ можна буде давати, коли Україна впорається з COVID-19.
-
![Перехід до адаптивного карантину: які заборони скасують]()
Степанов розповів про новий етап виходу з карантину.
-
![У Грузії за добу підтвердили лише один випадок COVID-19]()
За минулі 24 години в Грузії виявили всього лише один новий випадок зараження COVID-19.
-
![МОЗ повідомляє: в Україні зафіксовано 18876 випадків коронавірусної хвороби]()
Дані з тимчасово окупованих територій АР Крим, Донецької, Луганської областей та міста Севастополя відсутні.
-
![В Україні вже зробили понад 200 тисяч ПЛР-тестів]()
В Україні на цей час зроблено вже 227 тисяч ПЛР-тестів на коронавірус.
-
![Відома радянська актриса втекла з лікарні після тесту на COVID-19]()
У 73-річної артистки спостерігалися температура і сильний кашель.
-
!["Біофарма" починає проводити ІФА-тести донорів плазми, які перенесли COVID-19]()
Біофармацевтична компанія "Біофарма" розпочинає проводити ІФА-тести донорів плазми, котрі перенесли COVID-19, яку буде використано для розробки препарату для лікування цього захворювання.
-
![На Черкащині зафіксували понад 370 інфікованих Covid-19]()
Станом на 18 травня на Черкащині зареєстровано 372 інфікованих короновірусом особи, передає УНН із посиланням на дані КМУ.
-
![У Польщі кількість заражених Covid-19 перевищила 18,7 тисячі]()
Станом на 18 травня кількість заражених коронавірусом у Польщі зросла до 18 746, з яких 929 осіб померли, а 7 451 людина вилікувалася.
-
![В Україні за добу виявили 325 нових випадків коронавірусу]()
Станом на 18 травня в Україні лабораторно підтверджено 18 616 випадків COVID-19. За добу - 325 нових випадків.
-
![На Житомирщині в одному з районів зафіксували спалах коронавірус]()
У Любарському районі Житомирщини за минулу добу, 17 травня, лабораторно підтвердили 15 нових випадків коронавірусу.
-
![У світі вже зафіксували понад 4,8 мільйона випадків коронавірусу]()
На ранок 18 травня у світі загалом зафіксовано понад 4,8 мільйона випадків зараження коронавірусом, з них більше 316 тисяч - летальні.
-
![Кількість випадків коронавірусу б'ють антирекорди в Іраку]()
За минулу добу кількість нових випадків інфікування COVID-19 в Іраку зросла на 144, що є найвищим добовим приростом з початку епідемії.
-
![США звинуватили Китай у поширенні коронавірусу через туристів]()
У Трампа наголосили, що КНР "розповсюдила" вірус "ненавмисно".